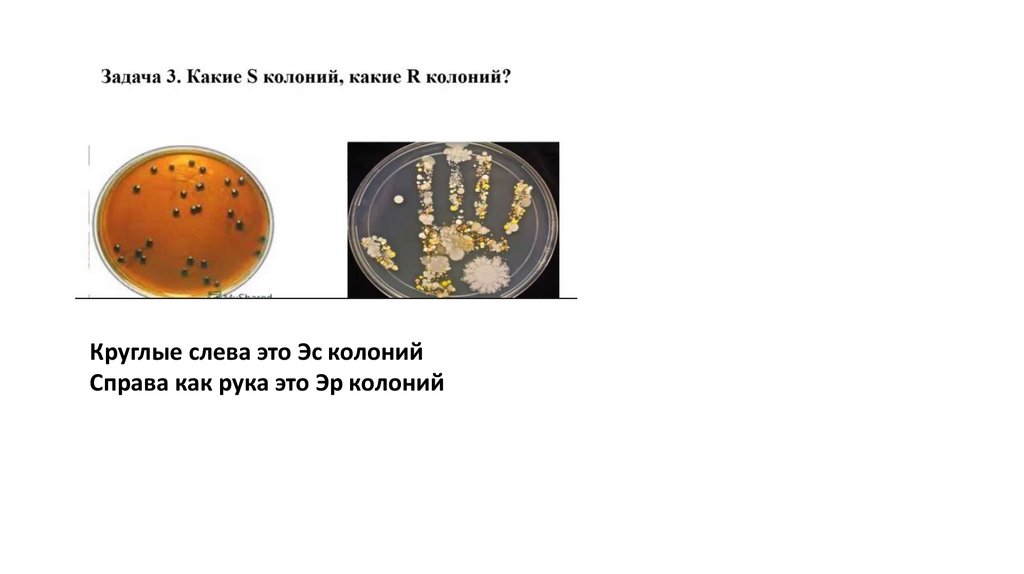

Similar presentations:
Иммуноферментный анализ
1.
Иммуноферментный анализ непрямой?метод основан на связывании АТ с АГ
второй еще метод сэндвича
2.
ТвердофазныйИммуноферментный анализ
Определение антигена в
сыворотке больного (в
лунках планшеток с
сорбированными
диагностическими
антителами)
твердофазный иммуноферментный анализ
Определение антител в сыворотке больного
(в лунках планшеток с сорбированным
антигеном
3.
Реакция прямой гемагглютинацииСклеивание эритроцитов
гемагглютининами вирусов
Реакция непрямой гемагглютинации
Склеивание эритроцитов антителами за счет
антигенов, адсорбированных на поверхности
эритроцитов
4.
ПЦРПолимеразная цепная реакция
метод молекулярно-генетической диагностики,
который позволяет выявить у человека
различные инфекционные и наследственные
заболевания, как в острой и хронической
стадии, так и задолго до того, как заболевание
может себя проявить.
5.
6.
Биологический методРеакция нейтрализации токсина
антитоксином
Для определения экзотоксина в
исследуемом материале
7.
Реакция коль преципетатции в пробирке8.
реакция преципитации в гелеРеакция коль преципетатции
в пробирке
9.
Реакция связявания комплиментаесли гемолиз есть то
ОТРИЦАТЕЛЬНАЯ
Реакция связывания комплимента
Если гемолиза нету то
ПОЛОЖИТЕЛЬНАЯ
10.
Реакция непрямойиммунофлюросенции
11.
Реакция торможения гемагглютинацииОпределения титра антител крови больного
ПОЛОЖИТЕЛЬНЫЙ зонтик
ОТРИЦАТЕЛЬНЫЙ пуговга
12.
реакция иммобилизации трепонем13.
14.
Непрямой иммуноферментныйанализ
15.
Стерелизация паромПинцеты, колбы, бактериологическая
игла, пинцет
16.
Совместное культивирование аэробов ианэробов
Метод фортнера
Метод Дригальского или посев
газоном
Посев шпателем
17.
Круглые слева это Эс колонийСправа как рука это Эр колоний
18.
1- Психрофилы2- мезофилы
3- термофилы
Для роста одного вида при этом
подавляют другой вид
применяют для накопления
Для определённой группы бактерий за
счёт создания условий, оптимальных
для одних видов и неблагоприятных
для других.
19.
Инструменты используемые для посевабактерий
А это бактериологическая петля
Б это шпатель
Варка бобовых ?
Анаэростат
Для культивирования облигатных
энаэробов в чашке петри
20.
Дыхательная гипоксия21.
Венозная гиперемия22.
асцит23.
24.
25.
26.
Глюкоза 6 фосфатдегидрогеназа27.
28.
Бактероцидныйоблучатель УФ
29.
Химический фактор30.
31.
Холестерин липопротеид низкойплотности
32.
Гиперпротеинемия ?33.
их мишенью являются бактериальные топоизомеразы:топоизомеразы IV и ДНК-гираза, ферменты,
осуществляющие синтез бактериальной ДНК
34.
35.
Положительная реакция связываниякомплимента
36.
2 – стадия резистентности.37.
Конъюгация38.
Экссудативное воспалениеГнойный экссудат
39.
Когерентное рассеяние40.
Высокая температура41.
Барометрическое давление42.
Непрямой иммуноверментный43.
Атеросклероз44.
45.
протоонкоген46.
макролиды47.
Ацидоз и гиперкапния48.
Местное применение: Тербинафин и КлотримазолСистемное: Кетоконазол и Флуконазол
49.
С реактивный белок50.
Болезнь Фавизм51.
52.
53.
Реакция нейтрализации вирусов в культуреклеток
54.
Электрический ожог55.
Фильтрация56.
57.
Ишемия ?58.
59.
Бетталактамы60.
Инсулин уменьшение61.
Из-за барометрического давления62.
Гальванизация63.
ПЦР64.
тироксин65.
Дригальский / газон66.
У сцепленный67.
Инсулиновый шок ?68.
супероксиддисмутаза69.
Цифра 170.
Нестероидные противоспалительные препаратыклассификация: производные кислот и некислотные

medicine
medicine








